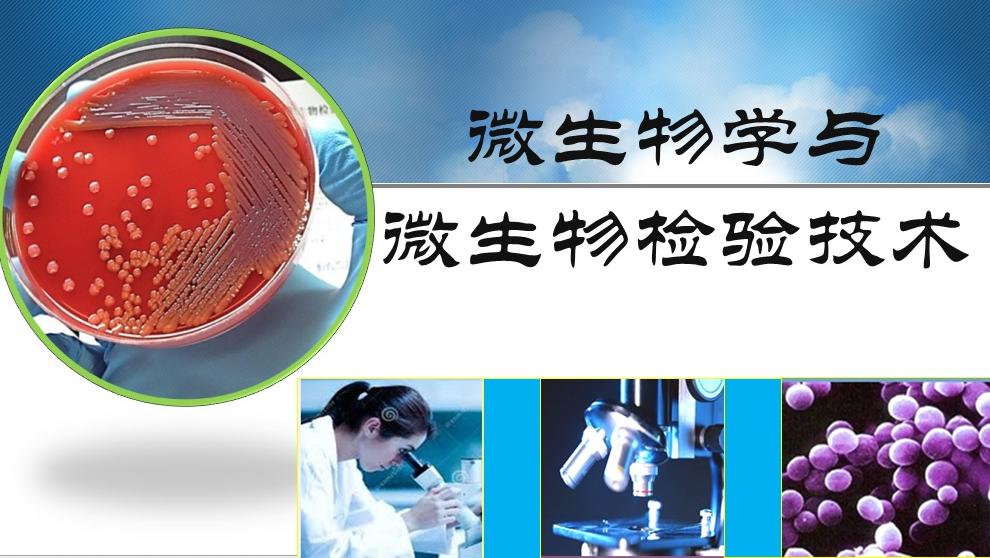
微生物学与微生物检验技术2019答案章节答案期末答案

微生物检验

标本直涂片在微生物检验中的意义
图片尺寸1048x715
食品微生物检测_检验
图片尺寸982x730
检验人员进行微生物检验观察.陈惠韶摄
图片尺寸1024x681
微生物方法学验证,抗生素含量(效价)测定;保健品,化妆品中微生物检
图片尺寸611x541
微生物学检验
图片尺寸1080x1133
微生物检测能力验证能力考核要点
图片尺寸640x415
在2017年1月至2017年12月接受的相关微生物检验标本中随机抽选500份
图片尺寸900x500
微生物学检验(第2版)
图片尺寸1000x1000
15-1976蛋制品卫生操作规程(包括灭菌蛋制品的微生物要求)ccaa 0007
图片尺寸840x480
同时对医院感染中的微生物检验和医院环境的微生物学调查,保证灭菌
图片尺寸1024x685
微生物检测
图片尺寸1289x716
我院检验科微生物室开展细菌快速鉴定--maldi-tof ms
图片尺寸1080x1440
检验科微生物实验室从0到1的过程分享
图片尺寸1024x683
cmi-1600-禾信康元质谱仪全自动微生物检测系统
图片尺寸674x454
微生物学与微生物检验技术2019答案章节答案期末答案
图片尺寸990x558
微生物检测
图片尺寸623x380
关于微生物浮游菌采样器型号推荐和操作指南
图片尺寸670x417
离病毒最近的人区疾控中心微生物检验科科长抗疫侦察兵朱姝
图片尺寸720x540
食品微生物检测实训第四期报道帖
图片尺寸668x622
《微生物检验技术》
图片尺寸1257x1756